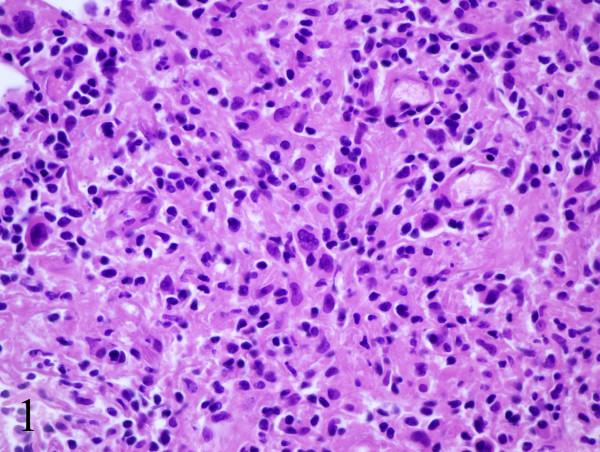
https://cdn.ncbi.nlm.nih.gov/pmc/blobs/587e/2211302/71e28230bf95/1752-1947-1-148-4.jpg

组织问题——霍奇金淋巴瘤患者接受ABVD化疗后发生结节病:一例报告
Tissue is the issue-sarcoidosis following ABVD chemotherapy for Hodgkin's lymphoma: a case report.
作者信息
Subbiah Vivek, Ly Uyen K, Khiyami Amer, O'Brien Timothy
机构信息
Division of Hematology/Oncology, Department of Medicine, Case Western Reserve University School of Medicine, MetroHealth Medical Center, Cleveland, Ohio, USA.
出版信息
J Med Case Rep. 2007 Nov 25;1:148. doi: 10.1186/1752-1947-1-148.
Thirty two year old Caucasian female presented 2 months post partum with fevers, cough and shortness of breath. CT scan of the chest to rule out pulmonary embolism revealed mediastinal lymphadenopathy. Biopsy of the nodes revealed classic Hodgkin's lymphoma and she received ABVD chemotherapy. She was in remission as confirmed by a PET/CT scan. Five months later she had another PET/CT scan which showed areas of hypermetabolism indicating a possible relapse. Biopsy revealed sarcoidosis. She received steroids and 18 months later remained in clinical remission. This rare case of sarcoid following classic Hodgkin's lymphoma illustrates that clinical presentation, physical exam, lab investigations and even PET/CT scans may not be able to discriminate between Hodgkin's lymphoma and sarcoidosis. Tissue biopsy and pathological diagnosis remain the gold standard.
一名32岁的白种女性产后2个月出现发热、咳嗽和呼吸急促。胸部CT扫描以排除肺栓塞,结果显示纵隔淋巴结肿大。淋巴结活检显示为经典型霍奇金淋巴瘤,她接受了ABVD化疗。经PET/CT扫描证实病情缓解。五个月后,她再次进行PET/CT扫描,结果显示代谢亢进区域,提示可能复发。活检显示为结节病。她接受了类固醇治疗,18个月后仍处于临床缓解状态。这个经典型霍奇金淋巴瘤后发生结节病的罕见病例表明,临床表现、体格检查、实验室检查甚至PET/CT扫描可能无法区分霍奇金淋巴瘤和结节病。组织活检和病理诊断仍然是金标准。